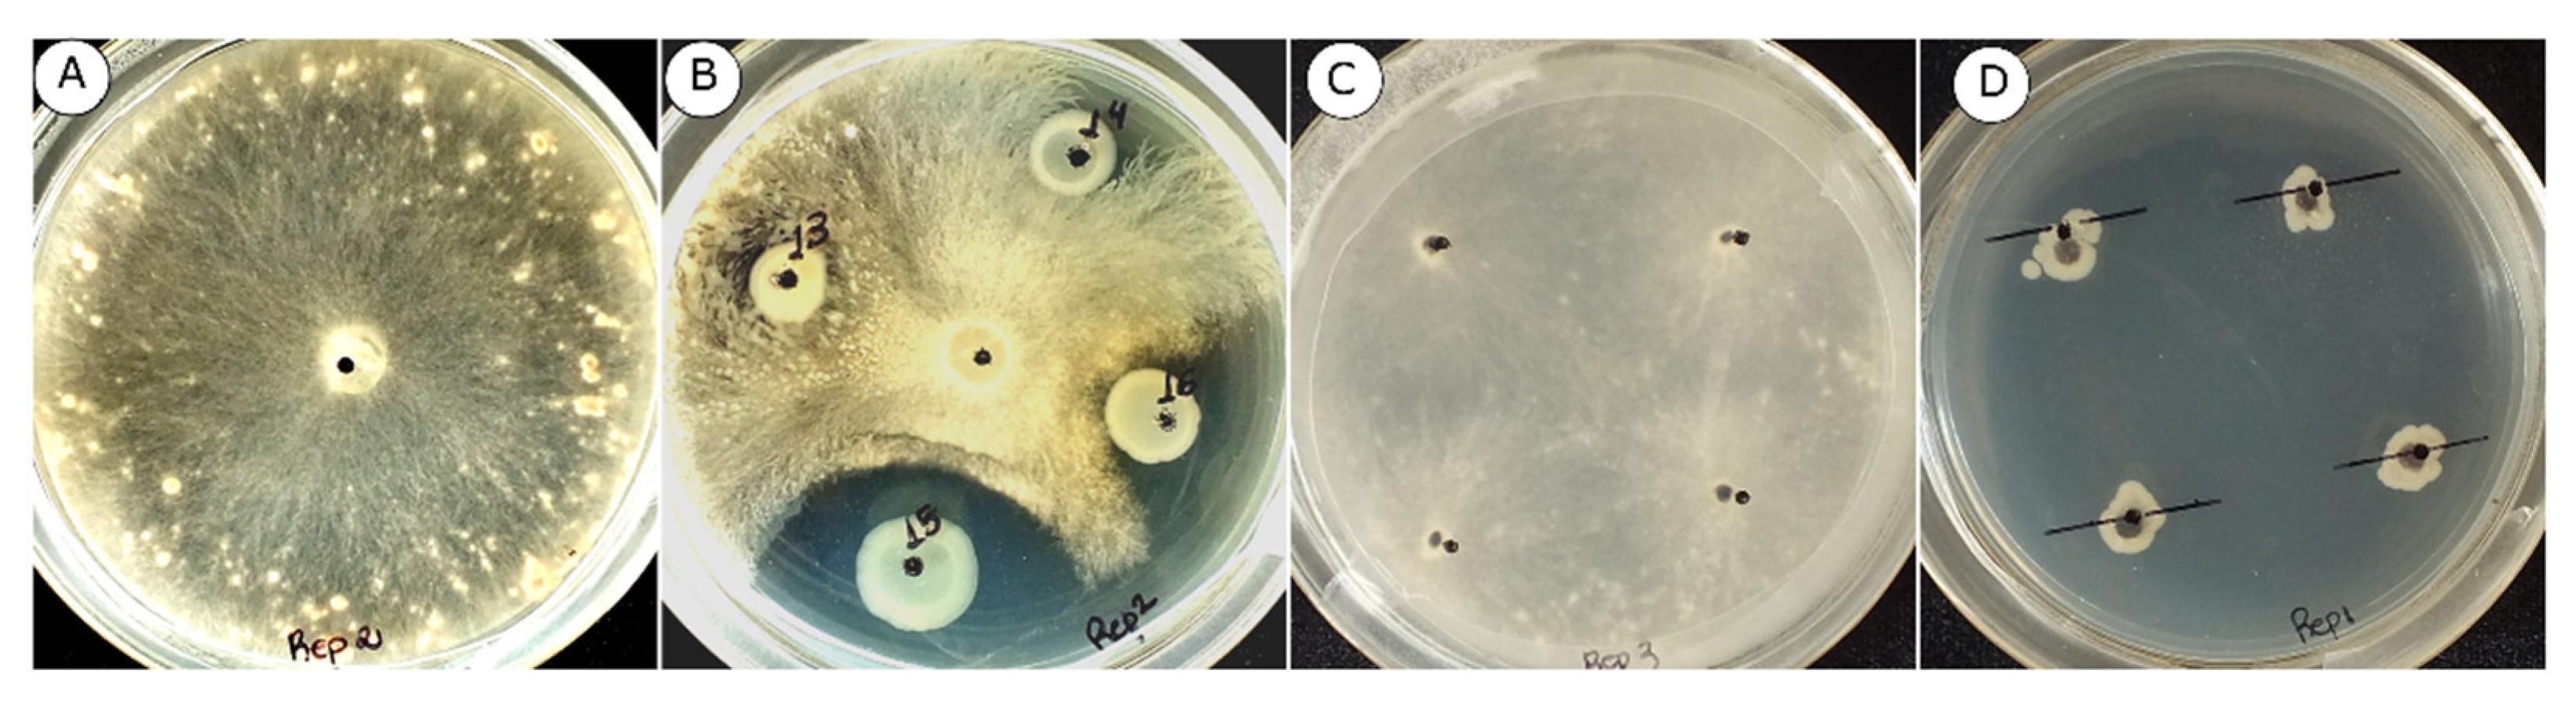
Agronomy 12 01395 g001 Agronomy 12 01395 g001
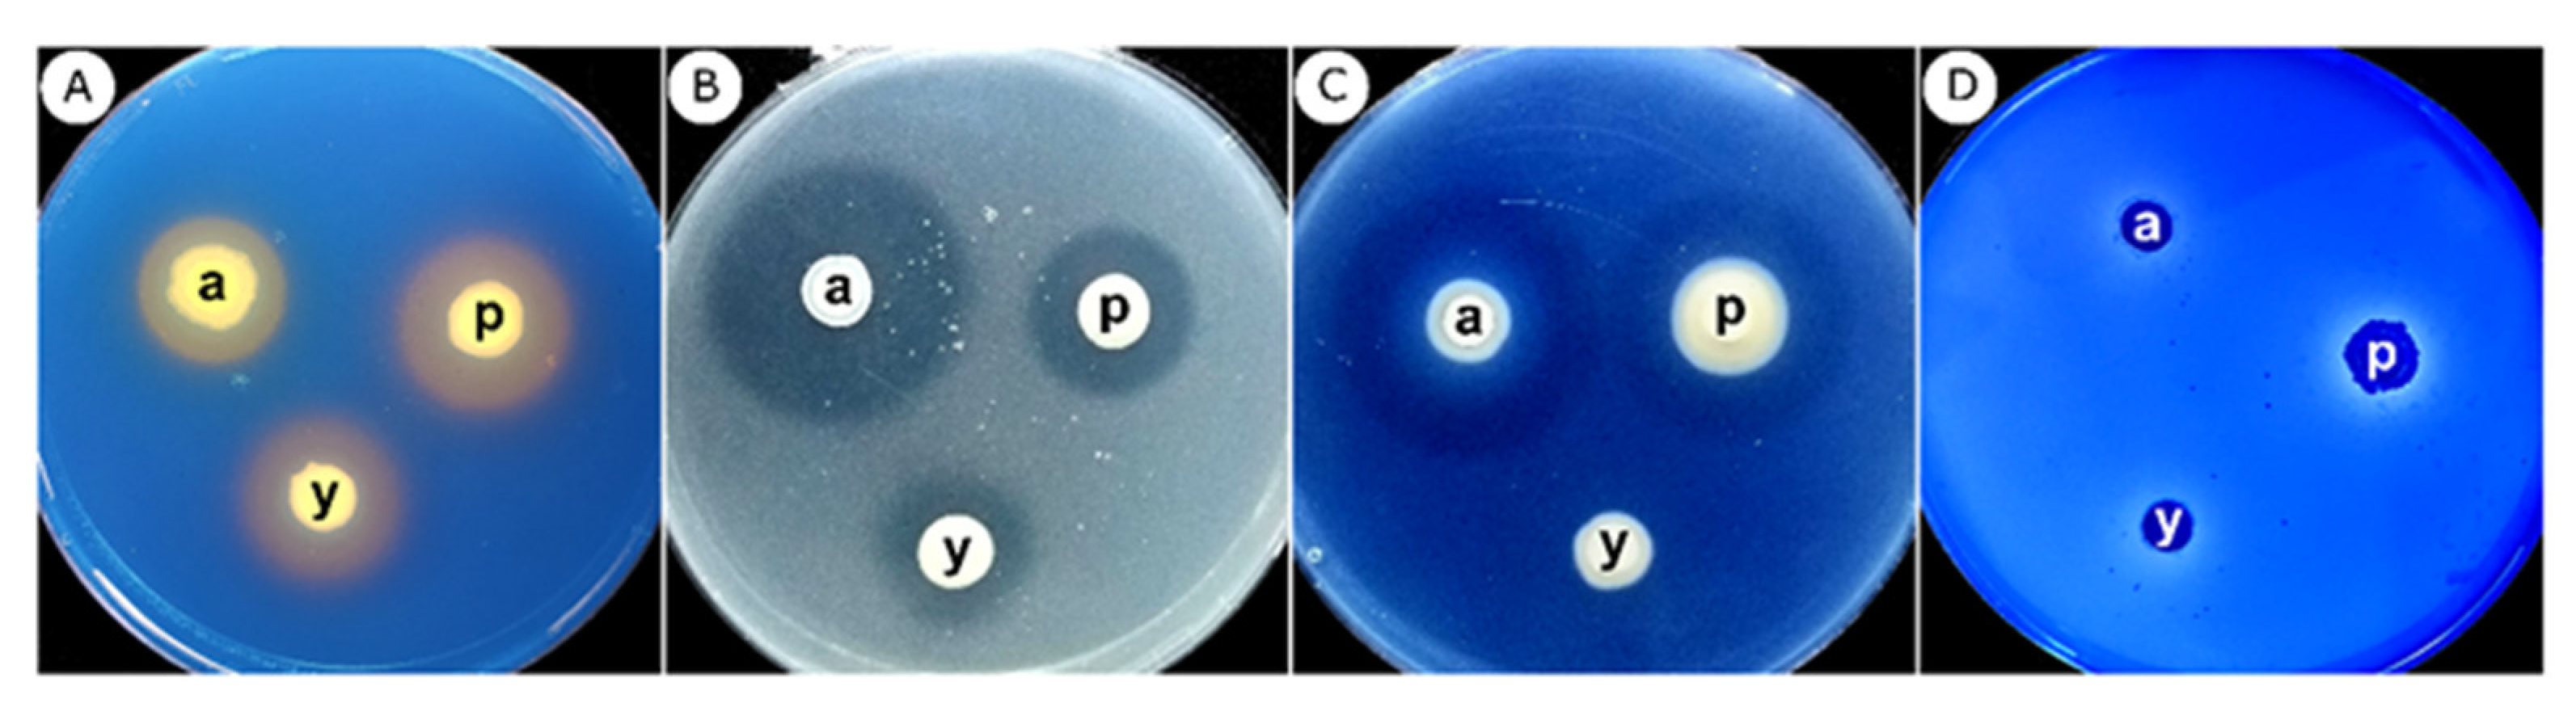
Agronomy 12 01395 g005 Agronomy 12 01395 g005

Bioprospecting Fluorescent Pseudomonas from the Brazilian Amazon for the Biocontrol of Signal Grass Foliar Blight
Abstract
1. Introduction
2. Materials and Methods
2.1. Sampling and Isolation of Pseudomonas Species from Amazonian Soils
2.2. Potential of Fluorescent Pseudomonas from the Amazon Soils as Biocontrol Agents
2.2.1. In Vitro Mycelial Growth Inhibition of R. solani AG-1 IA
2.2.2. In Vitro Inhibition of R. Solani AG-1 IA Sclerotial Germination
2.2.3. In Vivo Biocontrol of Rhizoctonia Foliar Blight by Fluorescent Pseudomonas Delivered as Seed Treatment
2.2.4. In Vivo Biocontrol of Rhizoctonia Foliar Blight by Fluorescent Pseudomonas Delivered by Foliar Spray
2.3. Phylogenetics Identification of Fluorescent Pseudomonas
2.3.1. DNA Extraction
2.3.2. PCR Reactions and Sequencing of the 16S rDNA Region and rpoB Genes
2.3.3. Phylogenetics Identification
2.4. Potential Biological Control Mechanisms
2.4.1. Protease, Chitinase, and Cellulase Activity Measurements
2.4.2. Detection of Siderophore Production
2.4.3. Detection of Phosphate Solubilization
3. Results
3.1. Mycelial Growth and Sclerotia Germination of R. Solani AG-1 IA
3.2. Potential of Pseudomonas spp. for in vivo Biocontrol of the Leaf Blight Disease on Signal Grass
3.2.1. Seed Treatment with Fluorescent Pseudomonas
3.2.2. Foliar Application of Fluorescent Pseudomonas
3.3. Molecular Identification of Fluorescent Pseudomonas from Amazonian Soils
3.4. In Vitro Detection of Protease, Cellulase, and Chitinase Activities of Fluorescent Pseudomonas Isolates
3.5. Qualitative Detection of Siderophore Production and Phosphate Solubilization
4. Discussion
5. Conclusions
Supplementary Materials
Author Contributions
Funding
Institutional Review Board Statement
Informed Consent Statement
Data Availability Statement
Acknowledgments
Conflicts of Interest
References
- Kelemu, S.; Miles, J.W.; Bonilla, X.P.; Badel, J.L. Sources of resistance in species of Brachiaria to foliar blight disease caused by Rhizoctonia solani. Trop. Grassl. 1995, 29, 257–262. [Google Scholar]
- González-Vera, A.D.; Bernardes-de-Assis, J.; Zala, M.; McDonald, B.A.; Correa-Victoria, F.; Graterol-Matute, E.J.; Ceresini, P.C. Divergence between sympatric rice- and maize-infecting populations of Rhizoctonia solani AG-1 IA from Latin America. Phytopathology 2010, 100, 172–182. [Google Scholar] [CrossRef] [PubMed]
- Chavarro Mesa, E.; Ceresini, P.C.; Ramos Molina, L.M.; Pereira, D.A.S.; Schurt, D.A.; Vieira, J.R.; Poloni, N.M.; McDonald, B.A. The Urochloa foliar blight and collar rot pathogen Rhizoctonia solani AG-1 IA emerged in South America via a host shift from rice. Phytopathology 2015, 105, 1475–1486. [Google Scholar] [CrossRef] [PubMed]
- Duarte, M.d.L.R.; Albuquerque, F.C.; Sanhueza, R.M.V.; Verzignassi, J.R.; Kondo, N. Etiologia da podridão do coleto de Brachiara brizantha em pastagens da Amazônia. Fitopatol. Bras. 2007, 32, 261–265. [Google Scholar] [CrossRef]
- Verzignassi, J.R.; Fernandes, C.D. Doenças em Forrageiras; Divulgação Técnica; Embrapa Gado de Corte: Campo Grande, Brazil, 2001; n. 50; 3p. [Google Scholar]
- Vieira Júnior, J.R.; Fernandes, C.F.; Marreios, J.A.A.; Sangi, S.C.; Fonseca, A.S.; Silva, D.S.G.; Alves, T.C.; Matos, A.I.; Maia, D. Levantamento da ocorrência da morte-das-pastagens em Rondônia; Comunicado Técnico; Embrapa Rondônia: Rodovia, Brazil, 2014; n. 394; 5p. [Google Scholar]
- Chavarro-Mesa, E.; Ceresini, P.; Pereira, D.; Vicentini, S.; Silva, T.; Ramos-Molina, L.; Negrisoli, M.; Schurt, D.; Vieira Júnior, J.R. A broad diversity survey of Rhizoctonia species from the Brazilian Amazon reveals the prevalence of R. solani AG-1 IA on signal grass and the new record of AG-1 IF on cowpea and soybeans. Plant Pathol. 2020, 69, 455–466. [Google Scholar] [CrossRef]
- Marchi, C.E.; Fernandes, C.D.; Verzignassi, J.R. Doenças em plantas forrageiras; Documentos; Embrapa Gado de Corte: Campo Grande, Brazil, 2011; n. 187; 28p. [Google Scholar]
- Lucas, J.A.; Hawkins, N.J.; Fraaije, B.A. The evolution of fungicide resistance. Adv. Appl. Microbiol. 2015, 90, 29–92. [Google Scholar]
- Nega, A. Review on Concepts in Biological Control of Plant Pathogens. J. Biol. Agric. Healthc. 2014, 4, 23. [Google Scholar]
- Weller, D.M. Pseudomonas biocontrol agents of soilborne pathogens: Looking back over 30 years. Phytopathology 2007, 97, 250–256. [Google Scholar] [CrossRef]
- Zago, V.C.P.; De-Polli, H.; Norma, G. Pseudomonas spp. Fluorescentes—Bactérias Promotoras de Crescimento de Plantas e Biocontroladoras de Fitopatógenos em Sistemas de Produção Agrícola; Documentos; Embrapa Agrobiologia: Rodovia, Brazil, 2000; n. 127; 32p. [Google Scholar]
- Ferreira, E.P.B.; Voss, M.; Santos, H.P.; De-Polli, H.; Neves, M.C.P.; Rumjanek, N.G. Diversidade de Pseudomonas fluorescentes em diferentes sistemas de manejo do solo e rotação de culturas. Agrárias-Rev. Bras. Ciências Aggrárias 2009, 4, 140–148. [Google Scholar] [CrossRef][Green Version]
- Höfte, M. The Use of Pseudomonas spp. as Bacterial Biocontrol Agents to Control Plant Disease; Köhl, J., Ravensberg, W., Eds.; Microbial Bioprotectants for Plant Disease Management; Burleigh Dodds Science Publishing: Cambridge, UK, 2022; pp. 1–72. [Google Scholar]
- Panpatte, D.G.; Jhala, Y.K.; Shelat, H.N.; Vyas, R.V. Pseudomonas fluorescens: A Promising Biocontrol Agent and PGPR for Sustainable Agriculture. In Microbial Inoculants in Sustainable Agricultural Productivity: Vol. 1: Research Perspectives; Singh, D.P., Singh, H.B., Prabha, R., Eds.; Springer: New Delhi, India, 2016; pp. 257–270. [Google Scholar]
- D’aes, J.; Hua, G.K.H.; De Maeyer, K.; Pannecoucque, J.; Forrez, I.; Ongena, M.; Dietrich, L.E.P.; Thomashow, L.S.; Mavrodi, D.V.; Höfte, M. Biological Control of Rhizoctonia Root Rot on Bean by Phenazine- and Cyclic Lipopeptide-Producing Pseudomonas CMR12a. Phytopathology 2011, 101, 996–1004. [Google Scholar] [CrossRef]
- Olorunleke, F.E.; Hua, G.K.H.; Kieu, N.P.; Ma, Z.; Höfte, M. Interplay between orfamides, sessilins and phenazines in the control of Rhizoctonia diseases by Pseudomonas sp. CMR12a. Environ. Microbiol. Rep. 2015, 7, 774–781. [Google Scholar] [CrossRef]
- Vinay, J.U.; Naik, M.K.; Rangeshwaran, R.; Chennappa, G.; Shaikh, S.S.; Sayyed, R.Z. Detection of antimicrobial traits in fluorescent pseudomonads and molecular characterization of an antibiotic pyoluteorin. 3 Biotech 2016, 6, 227. [Google Scholar] [CrossRef] [PubMed]
- Páez, M.; Martínez-Nieto, P.; Bernal-Castillo, J. Siderophore producing Pseudomonas as pathogenic Rhizoctonia solani and Botrytis cinerea antagonists. Univ. Sci. 2005, 10, 65–74. [Google Scholar]
- Dimkpa, C. Microbial siderophores: Production, detection and application in agriculture and environment. Endocytobiosis Cell Res. 2016, 27, 7–16. [Google Scholar]
- Chen, C.; BÉLanger, R.R.; Benhamou, N.; Paulitz, T.C. Defense enzymes induced in cucumber roots by treatment with plant growth-promoting rhizobacteria (PGPR) and Pythium aphanidermatum. Physiol. Mol. Plant Pathol. 2000, 56, 13–23. [Google Scholar] [CrossRef]
- Bautista, G.; Mendoza Rivera, H.; Uribe-Vélez, D. Biocontrol of Rhizoctonia solani in native potato (Solanum phureja) plants using native Pseudomonas fluorescens. Acta Biológica Colomb. 2007, 12, 19–32. [Google Scholar]
- Rana, A.; Sahgal, M.; Kumar, P. Biocontrol Prospects of Pseudomonas fluorescens AS15 against Banded Leaf and Sheath Blight Disease of Maize under Field Condition in Conducive Soil. Natl. Acad. Sci. Lett. 2019, 42, 425–428. [Google Scholar] [CrossRef]
- Nagendran, S.; Kulanthaivelu, S.; Sundararajan, T. Assessment on antagonistic potential of Bacterial bio agents Pseudomonas fluorescens and Bacillus subtilis against Rhizoctonia solani Kühn. An incitant of Sheath blight of rice. J. Entomol. Zool. Stud. 2019, 7, 128–142. [Google Scholar]
- Mavrodi, O.V.; Walter, N.; Elateek, S.; Taylor, C.G.; Okubara, P.A. Suppression of Rhizoctonia and Pythium root rot of wheat by new strains of Pseudomonas. Biol. Control 2012, 62, 93–102. [Google Scholar] [CrossRef]
- Gould, W.D.; Hagedorn, C.; Bardinelli, T.R.; Zablotowicz, R.M. New Selective Media for Enumeration and Recovery of Fluorescent Pseudomonads from Various Habitats. Appl. Environ. Microbiol. 1985, 49, 28–32. [Google Scholar] [CrossRef]
- Lamari, L. Assess 2.0: Image Analysis Software for Plant Disease Quantification; American Phytopathological Society: St. Paul, MN, USA, 2008. [Google Scholar]
- Milling, A.; Smalla, K.; Maidl, F.X.; Schloter, M.; Munch, J.C. Effects of transgenic potatoes with an altered starch composition on the diversity of soil and rhizosphere bacteria and fungi. Plant Soil 2005, 266, 23–39. [Google Scholar] [CrossRef]
- Spilker, T.; Coenye, T.; Vandamme, P.; LiPuma, J.J. PCR-based assay for differentiation of Pseudomonas aeruginosa from other Pseudomonas species recovered from cystic fibrosis patients. J. Clin. Microbiol. 2004, 42, 2074–2079. [Google Scholar] [CrossRef]
- Tayeb, L.A.; Ageron, E.; Grimont, F.; Grimont, P.A.D. Molecular phylogeny of the genus Pseudomonas based on rpoB sequences and application for identification of isolates. Res. Microbiol. 2005, 156, 763–773. [Google Scholar] [CrossRef]
- Garrido-Sanz, D.; Meier-Kolthoff, J.P.; Göker, M.; Martín, M.; Rivilla, R.; Redondo-Nieto, M. Genomic and Genetic Diversity within the Pseudomonas fluorescens Complex. PLoS ONE 2016, 11, e0150183. [Google Scholar] [CrossRef]
- Girard, L.; Lood, C.; Höfte, M.; Vandamme, P.; Rokni-Zadeh, H.; van Noort, V.; Lavigne, R.; De Mot, R. The Ever-Expanding Pseudomonas Genus: Description of 43 New Species and Partition of the Pseudomonas putida Group. Microorganisms 2021, 9, 1766. [Google Scholar] [CrossRef] [PubMed]
- Hesse, C.; Schulz, F.; Bull, C.T.; Shaffer, B.T.; Yan, Q.; Shapiro, N.; Hassan, K.A.; Varghese, N.; Elbourne, L.D.H.; Paulsen, I.T.; et al. Genome-based evolutionary history of Pseudomonas spp. Environ. Microbiol. 2018, 20, 2142–2159. [Google Scholar] [CrossRef] [PubMed]
- Mulet, M.; Lalucat, J.; García-Valdés, E. DNA sequence-based analysis of the Pseudomonas species. Environ. Microbiol. 2010, 12, 1513–1530. [Google Scholar]
- Vásquez-Ponce, F.; Higuera-Llantén, S.; Pavlov, M.S.; Marshall, S.H.; Olivares-Pacheco, J. Phylogenetic MLSA and phenotypic analysis identification of three probable novel Pseudomonas species isolated on King George Island, South Shetland, Antarctica. Braz. J. Microbiol. 2018, 49, 695–702. [Google Scholar] [CrossRef]
- Ghose, T.K. Measurement of cellulase activities. Pure Appl. Chem. 1987, 59, 257–268. [Google Scholar] [CrossRef]
- Ahmadi, K.; Yazdi, M.; Najafi, M.; Shahverdi, A.R.; Faramarzi, M.; Zarrini, G.; Behravan, J. Optimization of Medium and Cultivation Conditions for Chitinase Production by the Newly Isolated: Aeromonas sp. Biotechnology 2008, 7, 266–272. [Google Scholar]
- Schwyn, B.; Neilands, J.B. Universal chemical assay for the detection and determination of siderophores. Anal. Biochem. 1987, 160, 47–56. [Google Scholar] [CrossRef]
- Souchie, E.; Abboud, A. Solubilização de fosfato por microrganismos rizosféricos de genótipos de Guandu cultivados em diferentes classes de solo. Semin. Ciências Agrárias 2007, 28, 11. [Google Scholar] [CrossRef][Green Version]
- Anzai, Y.; Kim, H.; Park, J.Y.; Wakabayashi, H.; Oyaizu, H. Phylogenetic affiliation of the pseudomonads based on 16S rRNA sequence. Int. J. Syst. Evol. Microbiol. 2000, 50 Pt 4, 1563–1589. [Google Scholar] [CrossRef] [PubMed]
- Adékambi, T.; Drancourt, M.; Raoult, D. The rpoB gene as a tool for clinical microbiologists. Trends Microbiol. 2009, 17, 37–45. [Google Scholar] [CrossRef]
- Peix, A.; Valverde, A.; Rivas, R.; Igual, J.M.; Ramírez-Bahena, M.H.; Mateos, P.F.; Santa-Regina, I.; Rodríguez-Barrueco, C.; Martínez-Molina, E.; Velázquez, E. Reclassification of Pseudomonas aurantiaca as a synonym of Pseudomonas chlororaphis and proposal of three subspecies, P. chlororaphis subsp. chlororaphis subsp. nov., P. chlororaphis subsp. aureofaciens subsp. nov., comb. nov. and P. chlororaphis subsp. aurantiaca subsp. nov., comb. nov. Int. J. Syst. Evol. Microbiol. 2007, 57, 1286–1290. [Google Scholar]
- Cenciani, K.; Lambais, M.R.; Cerri, C.C.; Azevedo, L.C.C.; Feigl, B.J. Bacteria diversity and microbial biomass in forest, pasture and fallow soils in the southwestern amazon basin. Rev. Bras. Ciência Solo 2009, 33, 907–916. [Google Scholar] [CrossRef]
- Vellasamy, S.; Nithya, K.; Hariharan, H.; Jayaprakashvel, M.; Balasubramanian, N. Biocontrol Mechanisms of Siderophores against Bacterial Plant Pathogens; Kannan, V.R., Bastas, K.K., Eds.; Sustainable Approaches for Controlling Plant Pathogenic Bacteria; CRC Press: Boca Raton, FL, USA, 2015; pp. 167–186. [Google Scholar]
- Reddy, B.P.; Rani, J.; Reddy, M.S.; Kumar, K.V.K. Siderophore isolation and its Biocontrol action against Rice Fungal Pathogens. Biochem. Mol. Biol. 2019, 1, 1–6. [Google Scholar]
- Rathore, R.; Vakharia, D.N.; Rathore, D.S. In vitro screening of different Pseudomonas fluorescens isolates to study lytic enzyme production and growth inhibition during antagonism of Fusarium oxysporum f. sp. cumini, wilt causing pathogen of cumin. Egypt. J. Biol. Pest Control 2020, 30, 57. [Google Scholar] [CrossRef]
- Bernardes, F.S.; Patrício, F.R.A.; Santos, A.S.; Freitas, S.d.S. Indução de resistência sistêmica por rizobactérias em cultivos hidropônicos. Summa Phytopathol. 2010, 36, 115–121. [Google Scholar] [CrossRef]
- Oteino, N.; Lally, R.D.; Kiwanuka, S.; Lloyd, A.; Ryan, D.; Germaine, K.J.; Dowling, D.N. Plant growth promotion induced by phosphate solubilizing endophytic Pseudomonas isolates. Front. Microbiol. 2015, 6, 745. [Google Scholar] [CrossRef]
- Prasanna, A.; Deepa, V.; Balakrishn, P.; Deecaraman, M.; Sridhar, R.; Dhandapani, P. Insoluble Phosphate Solubilization by Bacterial Strains Isolated from Rice Rhizosphere Soils from Southern India. Int. J. Soil Sci. 2011, 6, 134–141. [Google Scholar] [CrossRef]
- Nandakumar, R.; Babu, S.; Viswanathan, R.; Raguchander, T.; Samiyappan, R. Induction of systemic resistance in rice against sheath blight disease by Pseudomonas fluorescens. Soil Biol. Biochem. 2001, 33, 603–612. [Google Scholar] [CrossRef]
- Souza, F.H.D. Produção de Sementes de Gramíneas Forrageiras Tropicais; Embrapa Pecuária Sudeste: São Carlos, Brazil, 2001; p. 43. [Google Scholar]
- Akter, S.; Kadir, J.; Juraimi, A.S.; Saud, H.M. In vitro evaluation of Pseudomonas bacterial isolates from rice phylloplane for biocontrol of Rhizoctonia solani and plant growth promoting traits. J. Environ. Biol. 2016, 37, 597–602. [Google Scholar] [PubMed]
- Austin, B.; Dickinson, C.H.; Goodfellow, M. Antagonistic interactions of phylloplane bacteria with Drechslera dictyoides (Drechsler) Shoemaker. Can. J. Microbiol. 1977, 23, 710–715. [Google Scholar] [CrossRef] [PubMed]
- Kumar, K.; Raju, S.; Reddy, M.; Kloepper, J.; Lawrence, K.; Groth, D.; Miller, M.; Sudini, H.; Du, B. Evaluation of Commercially Available PGPR for Control of Rice Sheath Blight Caused by Rhizoctonia solani. J. Pure Appl. Microbiol. 2009, 3, 485–488. [Google Scholar]
- Subashri, R.; Gurusamy, R.; Sakthivel, N.; Raman, B.; Sakthivel, B.; Maheshwari, D. Biological Control of Pathogens and Plant Growth Promotion Potential of Fluorescent Pseudomonads; Maheshwari, D.K., Ed.; Bacteria in Agrobiology: Disease Management; Springer: Berlin/Heidelberg, Germany, 2012; pp. 77–110. [Google Scholar]
- MAPA. AGROFIT. Available online: http://extranet.agricultura.gov.br/agrofit_cons/principal_agrofit_cons (accessed on 20 December 2021).
- Oliver, C.; Hernández, I.; Caminal, M.; Lara, J.M.; Fernàndez, C. Pseudomonas putida strain B2017 produced as technical grade active ingredient controls fungal and bacterial crop diseases. Biocontrol Sci. Technol. 2019, 29, 1053–1068. [Google Scholar] [CrossRef]
- Ghini, R.; Bettiol, W. Proteção de plantas na agricultura sustentável. Cad. De Ciência Tecnol.—CC&T 2000, 17, 61–70. [Google Scholar]

| Gene | Primers | Sequences (5′–3′) | Length (bp) | Annealing Temperature (°C) | References | Fragment Length (bp) |
|---|---|---|---|---|---|---|
| 16S rDNA | F311-Ps | CTGGTCTGAGAGGATGATCAGT | 22 | 63 | Milling et al., 2004 [28] | 1150 |
| R1459-Ps | AATCACTCCGTGGTAACCGT | 20 | ||||
| 16S rDNA | PAGSF | GACGGGTGAGTAATGCCTA | 19 | 54 | Spilker et al., 2004 [29] | 618 |
| PAGSR | CACTGGTGTTCCTTCCTAA | |||||
| rpoB | LAPS | TGGCCGAGAACCAGTTCCGCGT | 22 | 60 | Tayeb et al., 2005 [30] | 1229 |
| LAPS27 | CGGCTTCGTCCAGCTTGTTCAG | 22 |
| Factor | Source of Variation | df | Mean Square | F | p |
|---|---|---|---|---|---|
| Inhibition of Mycelial growth | Experiments (E) | 1 | 116.19 | 2.156 | 0.142 NS |
| Treatments (T) | 23 | 2017.80 | 37.438 | 0.000 * | |
| E × T | 23 | 19.52 | 0.362 | 0.997 NS | |
| Error | 672 | 53.89 | |||
| Treatments | 23 | 2017.80 | 38.17 | 0.000 * | |
| Error | 696 | 52.85 | |||
| Inhibition of sclerotia germination | Experiments (E) | 1 | 226.88 | 1.915 | 1.074 NS |
| Treatments (T) | 23 | 4216.88 | 35.58 | 0.000 * | |
| E × T | 23 | 127.21 | 1.074 | 0.378 NS | |
| Error | 192 | 118.49 | |||
| Treatments | 23 | 4216.88 | 35.16 | 0.000 * | |
| Error | 216 | 119.92 |
| Experiments | Source of Variation | df | Mean Square | F | p |
|---|---|---|---|---|---|
| Seed treatment | Experiments (E) | 1 | 45.64 | 0.484 | 0.4900 NS |
| Treatments (T) | 7 | 1639.85 | 17.405 | 0.0000 * | |
| Blocks | 3 | 256.10 | 2.718 | 0.0556 NS | |
| E × T | 7 | 167.45 | 1.777 | 0.1155 NS | |
| Error | 45 | 94.21 | |||
| Treatments | 7 | 1639.85 | 15.509 | 0.000 * | |
| Blocks | 7 | 149.26 | 1.412 | 0.222 NS | |
| Error | 28 | 105.74 | |||
| Foliar treatment | Experiments (E) | 1 | 0.0036 | 0.000* | 0.9930 NS |
| Treatments (T) | 7 | 2562.04 | 55.282 | 0.0000 * | |
| Blocks | 4 | 79.66 | 1.719 | 0.1576 NS | |
| E × T | 7 | 10.27 | 0.222 | 0.9789 NS | |
| Error | 60 | 46.34 | |||
| Treatments | 7 | 2562.04 | 57.64 | 0.000 * | |
| Blocks | 9 | 41.24 | 0.923 | 0.507 NS | |
| Error | 63 | 44.44 |
| Pseudomonas Isolates | Production of Siderophores | Phosphate Solubilization | Enzymatic Activity | ||
|---|---|---|---|---|---|
| Protease | Chitinase | Cellulase | |||
| Amana | + | + | + | + | - |
| Poti | + | + | + | + | - |
| Yara | + | + | - | + | - |
Publisher’s Note: MDPI stays neutral with regard to jurisdictional claims in published maps and institutional affiliations. |
© 2022 by the authors. Licensee MDPI, Basel, Switzerland. This article is an open access article distributed under the terms and conditions of the Creative Commons Attribution (CC BY) license (https://creativecommons.org/licenses/by/4.0/).
Share and Cite
Vicentini, S.N.C.; de Carvalho, G.; Krug, L.D.; Nunes, T.C.; da Silva, A.G.; Moreira, S.I.; Gonçalves, L.M.d.D.P.; Silva, T.C.; Ceresini, P.C. Bioprospecting Fluorescent Pseudomonas from the Brazilian Amazon for the Biocontrol of Signal Grass Foliar Blight. Agronomy 2022, 12, 1395. https://doi.org/10.3390/agronomy12061395
Vicentini SNC, de Carvalho G, Krug LD, Nunes TC, da Silva AG, Moreira SI, Gonçalves LMdDP, Silva TC, Ceresini PC. Bioprospecting Fluorescent Pseudomonas from the Brazilian Amazon for the Biocontrol of Signal Grass Foliar Blight. Agronomy. 2022; 12(6):1395. https://doi.org/10.3390/agronomy12061395
Chicago/Turabian StyleVicentini, Samara Nunes Campos, Giselle de Carvalho, Loane Dantas Krug, Tiago Calves Nunes, Abimael Gomes da Silva, Silvino Intra Moreira, Lucas Matheus de Deus Paes Gonçalves, Tatiane Carla Silva, and Paulo Cezar Ceresini. 2022. "Bioprospecting Fluorescent Pseudomonas from the Brazilian Amazon for the Biocontrol of Signal Grass Foliar Blight" Agronomy 12, no. 6: 1395. https://doi.org/10.3390/agronomy12061395
APA StyleVicentini, S. N. C., de Carvalho, G., Krug, L. D., Nunes, T. C., da Silva, A. G., Moreira, S. I., Gonçalves, L. M. d. D. P., Silva, T. C., & Ceresini, P. C. (2022). Bioprospecting Fluorescent Pseudomonas from the Brazilian Amazon for the Biocontrol of Signal Grass Foliar Blight. Agronomy, 12(6), 1395. https://doi.org/10.3390/agronomy12061395

